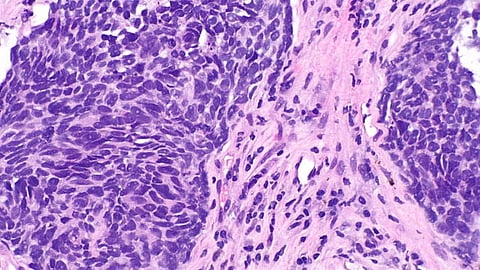

Corticosteroids, a commonly prescribed medication to alleviate cancer-related symptoms for non-small cell lung cancer patients treated with immunotherapy, are the main reason certain immunotherapies may fail in treating the disease, according to new research by Keck Medicine of USC.
The study [1], published today in Cancer Research Communications, showed that high doses of steroids, when given before and/or during a specific type of immunotherapy, caused patients’ tumors to shrink less than those of patients not on steroids. Those patients also did not live as long.
Additionally, researchers believe they have found the mechanism behind why steroids and some immunotherapies may not mix.
Ito and his colleagues also discovered that steroids blocked circulating biomarkers in the body — bits of cells in the bloodstream that signal when cancer is progressing so oncologists can adjust the patient’s treatment.
“Without the presence of circulating biomarkers to inform our decisions, oncologists cannot treat the cancer as effectively and patients may miss out on the best treatment for their cancer,” said Ito.
"Our findings reveal that steroids stop the body’s natural cancer-fighting cells, T-cells, from maturing. This makes them unable to attack the cancer as vigorously as they usually would, leading to worse outcomes for patients,” said Ito, who is also a member and co-leader of the translational and clinical sciences research program at USC Norris Comprehensive Cancer Center.
“While other research has indicated steroids may negatively impact immunotherapy’s efficacy, we are one of the first to pinpoint a probable cause and effect.”
The study examined the effect of steroids on a type of immunotherapy known as immune checkpoint inhibitors (ICIs). ICIs help the body's immune system fight cancer by blocking proteins that prevent T-cells from attacking cancer cells. ICIs are often used to treat non-small cell lung cancer, the most common form of lung cancer.
Steroids are often prescribed to alleviate symptoms of the cancer or treatments given for a variety of reasons, such as fatigue and vomiting, or more serious side effects like brain swelling and lung inflammation. Steroids suppress the immune system, which reduces the inflammation that can cause these conditions.
Ito and fellow researchers retrospectively studied the medical records of 277 patients with Stage II-IV non-small cell lung cancer who were treated with ICIs alone or in combination with other therapies. They compared outcomes (tumor shrinkage and survival rate) between patients prescribed steroids and those who were not at three centers, including USC Norris Comprehensive Cancer Center.
They analyzed up to eight years of data to determine that steroids were the sole factor impeding the effectiveness of the immunotherapy.
They also determined that the T-cells of significant numbers of patients on steroids were not fully matured and launched a preclinical study using mice to observe the effects of steroids on ICI therapy in real time. This mouse model study led to the discovery that steroids given before/during immunotherapy inhibit T-cells from fully maturing.
While the Keck Medicine research indicates steroids can interfere with ICIs, Ito acknowledges that for some patients, steroids may be necessary to manage their cancer-related symptoms.
We know that steroids will continue to play an important role in lung cancer care, but it is important to understand their potential limitations. Each patient should talk to their oncologist to make sure they have the best possible care plan tailored to their specific needs.
Fumito Ito, MD, PhD, lead author of the research, Keck Medicine oncologist and immunologist
He hopes this research will lead to more studies examining the effect of steroids on immunotherapy so oncologists can make fully informed decisions that will best benefit their patients.
Other study authors include Keck Medicine medical oncologists Jorge Nieva, MD and Robert Hsu, MD.
The study was supported with grants from the National Cancer Institute, P30CA016056 (RPCCC), P30CA014089 (USC), K08CA197966, R01CA255240, R01CA272827 (F. Ito), R01CA188900, R01CA267690 (B.H. Segal) as well as the Department of Defense Lung Cancer Research Program and the Uehara Memorial Foundation.
Reference:
1. Polyakov, Lauren, Angelina Lim, Alexandra Meyer, Aubree Mades, Joshua Ni, Ryan Cooper, Shirley Ye, et al. “Impact of Glucocorticoids on Immune Checkpoint Inhibitor Efficacy and Circulating Biomarkers in Non–Small Cell Lung Cancer Patients.” Cancer Research Communications 5, no. 7 (July 1, 2025): 1082–1094. https://doi.org/10.1158/2767-9764.CRC-25-0051.
(Newswise/TAK/MSM)